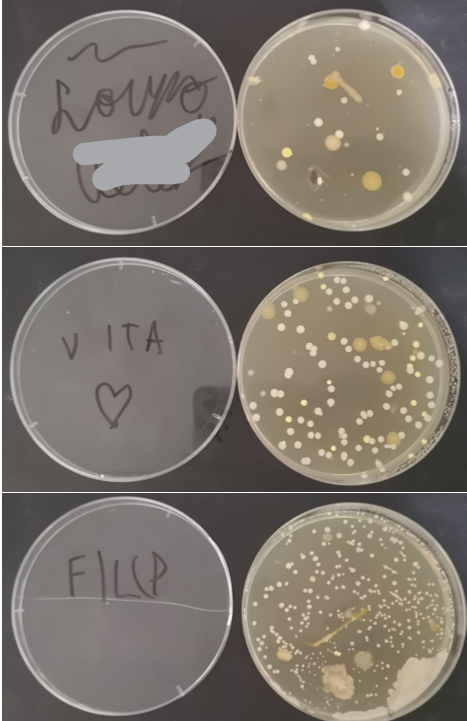

Učenici trećih razreda, polaznici izvannastavne skupine Galović Sveznadar su u petak 02 06. 2023. s učiteljicom Tatjanom Orešković sudjelovali na izvanrednom događaju koji je organizirao Institut za fiziku i Institut Ruđer Bošković pod nazivom Frizbijada.
‘Frizbijada’ je jedinstven znanstveno-popularni događaj nastao u sinergiji dva susjedna instituta s dokazanom predanošću i dugogodišnjim iskustvom u edukaciji i popularizaciji znanosti.
Europska komisija proglasila je 2023. godinu Europskom godinom vještina. Stoga je Frizbijada posebno usmjerena na jačanje znanstvenih vještina i osnaživanje učenika i studenata za budućnost koja je pred njima. Frizbijada nije običan dan otvorenih vrata, to je prilika za posjetitelje svih uzrasta da rasplamsaju svoju maštu, otkriju neke nove vještine i dožive ljepotu znanja i znanosti na djelu.
Na Frizbijadi je bilo za svakoga ponešto. Galović Sveznadare je najviše zanimala ENERGIJA jer su se cijele godine bavili tom temom u sklopu projekta FIRST LEGO League EXPLORE. Osmišljavali su razna rješenja kako bi potakli Održivi razvoj i racionalno trošenje električne energije.
Nekoliko rečenica trećaša:
„ Uz pomoć znanstvenika otkrili smo puno novih i zanimljivih pokusa. Nije mi baš jasno kako sve to funkcionira ali je bilo baš zabavno.“
„ Oduševljeni smo levitirajućim vlakićem, magnetima, suhim ledom, sintićem koji svira uz pomoć laserskih zraka, pisanjem tajnih poruka…“
„Meni su bili najbolji , mikroskopi, teleskop i detektor.“
„Učiteljice, molim Vas da idemo i druge godine na Frizbijadu“
Ček, a gdje frizbi?
Saznali smo da je FRIZBI akronimom dobiven iz skraćenica instituta, IRB i IF te riječi znanost. Galović Sveznadari su pohvalili znanstvenike i oduševili se njihovom kreativnošću. „Pa kako su to super smislili!“ 😊
Osim što smo posjetili tri laboratorija, prošli sve sadržaje u šatorima koje su postavili u perivoju i na travnjacima Instituta za fiziku na dar smo dobili i FRIZBI i Jo-jo. Baš lijepa uspomena na Frizbijadu.
U nastavku upoznajte buduću generaciju znanstvenika.
Što sve raste na našim rukama. Nakon uzimanja uzorka, uzgojili su bakterije i poslali nam snimke.